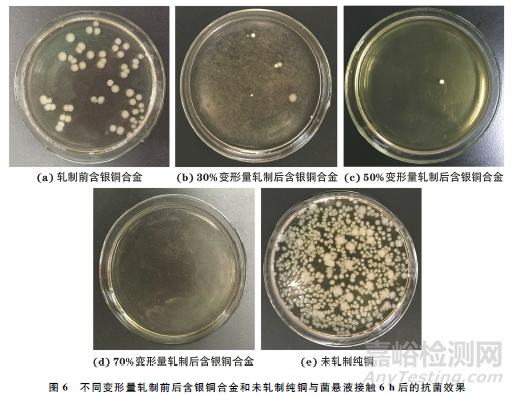

在室溫下對含質(zhì)量分?jǐn)?shù)0.11%銀的銅合金進(jìn)行軋制�,研究了軋制變形量(30%��,50%��,70%)對其組織和抗菌性能的影響����。結(jié)果表明:含銀銅合金的晶粒尺寸隨軋制變形量的增加而減小�,當(dāng)軋制變形量為70%時,平均晶粒尺寸由未軋制的143μm減小至1.4μm�,變形孿晶減少至基本消失;含銀銅合金中存在納米銀顆粒����,且偏聚在晶界處位錯墻、位錯纏結(jié)等缺陷密度較大區(qū)域��,軋制后納米銀顆粒分布均勻�����;軋制有利于提高含銀銅合金的抗菌性能,且變形量越大��,抗菌性能越好�,70%變形量軋制后含銀銅合金與大腸桿菌懸液接觸6h時的抗菌率超過99.9%,且抗菌效果可持續(xù)12h以上�,這與提高軋制變形量可增加合金中的缺陷數(shù)量和晶界密度,促進(jìn)納米銀顆粒的彌散分布有關(guān)��。
1 試樣制備與試驗方法
試驗材料為含銀銅合金�����,對比材料為純度99.95%的純銅�����。采用水刀將試驗材料切割成尺寸為100mm×20mm×20mm 的板條試樣�����,在軋機(jī)上進(jìn)行室溫軋制��,軋制變形量分別為30%����,50%���,70%,軋制速度為50mm·s-1����,每一變形量下軋制4道�����,每道次的下壓量相等��,軋制后試樣的平均厚度分別為14.12�,9.96,5.89mm�����。
采用線切割方法截取金相試樣并選取試樣橫向(TD)面作為后續(xù)觀察和測試面����,具體位置如圖1所示,圖中RD為軋制方向���,ND為軋制面的法向�����。對試樣進(jìn)行打磨�����、拋光�,用FeCl3、HCl��、H2O組成的溶液腐蝕5~10s后�����,采用光學(xué)顯微鏡觀察顯微組織��。采用電解雙噴方法制備透射電鏡試樣��,雙噴液為質(zhì)量分?jǐn)?shù)20%硝酸+80%甲醇的混合溶液����,環(huán)境溫度為-30℃,電流為10mA���,在透射電子顯微鏡(TEM)上觀察微觀形貌�����。按照GB/T 21510—2008和JIS Z 2801—2000����,采用覆膜法測試抗大腸桿菌性能,即將菌落數(shù)約為5×105cfu·mL-1大腸埃希氏標(biāo)準(zhǔn)菌懸液覆膜接種于相同表面積試樣平面上�����,在培養(yǎng)箱中恒溫恒濕培養(yǎng)6h和12h后��,將該大腸桿菌懸液按一定比例稀釋并繼續(xù)在瓊脂培養(yǎng)基中培養(yǎng)24h得到肉眼可見的菌落�����,統(tǒng)計各試樣的菌落數(shù)����,計算抗菌率R�,計算公式為

為探究含銀銅合金的抗菌持久性能,對已進(jìn)行抗菌試驗的合金表面分別采用保持原狀���、蒸餾水沖洗1min����、320#~1000#金相砂紙逐級打磨等方式進(jìn)行處理,而后采用相同的方法(覆膜法)進(jìn)行第二次和第三次抗菌試驗��,測試合金的抗菌性能���,大腸桿菌懸液接種于合金表面的培養(yǎng)時間為12h�。
2 試驗結(jié)果與討論
2.1 顯微組織
由圖2可知�,軋制前含銀銅合金中存在孿晶,且孿晶沿晶界生長逐漸穿過晶粒內(nèi)部而形成穿晶型孿晶(圖中圓圈位置所示)��,其形成機(jī)制主要是晶界生長過程中出現(xiàn)的層錯和不全位錯的運(yùn)動����。采用截線法計算得到軋制前含銀銅合金的平均晶粒尺寸為143μm。經(jīng)過30%變形量軋制后���,晶粒內(nèi)分布著大量寬度在1~5μm范圍的變形孿晶��,這是由于銅為面心立方晶體結(jié)構(gòu)����,層錯能低���,當(dāng)晶界在變形過程中滑移受阻且切應(yīng)力積累到足夠大時���,在位錯聚集處將以極快的速率形成薄片狀孿晶�;此時平均晶粒尺寸為32μm�����。增加軋制變形量后�����,含銀銅合金中的晶粒沿軋制方向明顯拉長��,孿晶數(shù)量降低���,平均晶粒尺寸減小。當(dāng)軋制變形量增加到70%時��,晶粒變形加劇��,晶界密度增加��,平均晶粒尺寸僅為1.4μm�����,此時變形孿晶幾乎消失,這是因為相鄰亞晶以凸出機(jī)制逐漸吞并變形孿晶�����,致使孿晶減少直到消失��。
2.2 微觀形貌
由圖3可以看出�,未軋制含銀銅合金組織中存在條帶狀結(jié)構(gòu),該結(jié)構(gòu)為胞帶�,胞帶間互相平行且分布較均勻,胞帶邊界有較多位錯以及位錯運(yùn)動增殖形成的位錯胞����,同時組織中還存在由位錯纏結(jié)形成的位錯墻。材料冷卻收縮時����,在內(nèi)應(yīng)力作用下組織內(nèi)部位錯發(fā)生滑移、增殖����,位錯密度增大且相互纏結(jié),此時一些異號位錯相互抵消��,剩下的位錯發(fā)生聚集而形成位錯墻,當(dāng)位錯墻圍成一個個獨立����、無位錯的區(qū)域時,便形成位錯胞���,位錯胞有規(guī)律地排列便形成胞帶�。
由圖4可以看到�,未軋制含銀銅合金中存在許多均勻分布的納米尺度顆粒(明場像中呈黑色,暗場像中呈亮白色)�����,推測這些微小顆粒為微量元素偏聚形成����。相比位錯胞內(nèi)部的無位錯區(qū)域�����,位錯墻周邊分布著較密集的黑色顆粒�,但僅通過明暗場像無法判斷這些黑色顆粒的結(jié)構(gòu)和成分,因此對試樣進(jìn)一步做TEM衍射花樣標(biāo)定��。
由圖5可以看出:未軋制含銀銅合金基體為具有面心立方晶體結(jié)構(gòu)的銅,晶帶軸為[011]����,黑色顆粒為具有面心立方晶體結(jié)構(gòu)的銀,晶帶軸為[100]�����。結(jié)合圖4可以判斷出�����,含銀銅合金中的顆粒為納米銀顆粒��,且納米銀在缺陷密度較大的晶界處偏聚����。常溫下銀在銅中的固溶度極低,極易析出導(dǎo)致基體中出現(xiàn)銀顆粒���;同時銀原子溶入晶格內(nèi)導(dǎo)致晶格點陣畸變��,產(chǎn)生應(yīng)力場�����,而在缺陷密度大的區(qū)域(位錯墻�、位錯纏結(jié)等)會形成較強(qiáng)應(yīng)力場并與位錯周圍的彈性應(yīng)力場交互作用,導(dǎo)致納米銀顆粒在缺陷附近偏聚��。ZHU等和ZUO等均發(fā)現(xiàn)����,塑性變形會細(xì)化含銀銅合金晶粒,促使納米銀顆粒彌散分布���。軋制變形后�����,合金中晶界密度增大�����,結(jié)合銀原子易富集在缺陷處的分布規(guī)律���,可以推斷納米銀顆粒仍會偏聚于缺陷密度較大的晶界處��,且其分布更加均勻。增加變形量會繼續(xù)提升晶界密度��,從而進(jìn)一步促使納米銀顆粒均勻分布�。
2.3 抗菌性能
圖6中白色點狀物即為大腸桿菌。由圖6可以看出:與未軋制純銅表面作用6h后的菌懸液經(jīng)培養(yǎng)后所得菌落大量繁殖��,而與未軋制含銀銅合金及軋制后含銀銅合金表面接觸6h后��,菌落數(shù)量明顯減少����,說明大腸桿菌的生長增殖受到了抑制;隨著軋制變形量的增加��,菌落數(shù)量減少��,與70%變形量軋制后含銀銅合金接觸并培養(yǎng)的菌懸液中幾乎沒有繁殖菌落�。
表1 不同變形量軋制前后含銀銅合金和未軋制純銅與菌懸液接觸不同時間的菌落數(shù)和抗菌率
由表1可以看出:與未軋制純銅表面接觸6,12h后的菌懸液經(jīng)培養(yǎng)后所得菌落數(shù)分別為8.36×105��,7.62×105cfu·mL-1����,均大于原菌懸液菌落數(shù),說明在與純銅接觸過程中����,大腸桿菌處于生長繁殖的狀態(tài)�����,此時抗菌率可以認(rèn)為是0����;與菌懸液接觸6h后���,不同變形量軋制前后含銀銅合金的抗菌率均大于90%��,且軋制后含銀銅合金的抗菌率均大于99%��,與菌懸液接觸12h后��,含銀銅合金的抗菌率均有所提高�����,且軋制后含銀銅合金的抗菌率高達(dá)99.9%以上��。按照SN/T 2399—2010�����,抗菌率符合Ⅰ級(抗菌率不低于99%)的抗菌金屬材料可以認(rèn)為有強(qiáng)抗細(xì)菌作用����,可知軋制可以提高含銀銅合金的抗菌效果����。含銀銅合金在軋制過程中受到三向應(yīng)力(二向壓應(yīng)力和一向拉應(yīng)力)的強(qiáng)烈作用,晶粒被壓扁拉長而得到細(xì)化�,晶界密度顯著增加,組織中形成大量位錯纏結(jié)����、位錯墻、位錯胞等缺陷�����,這些均促進(jìn)了納米銀顆粒均勻分布,使納米銀顆粒直接與細(xì)菌接觸的面積更大���,破壞菌體結(jié)構(gòu)����、紊亂新陳代謝的程度更高�����,從而表現(xiàn)出更強(qiáng)的抗菌效果。提高軋制變形量會進(jìn)一步增加合金中的缺陷數(shù)量和晶界密度�����,進(jìn)一步促進(jìn)納米銀顆粒的彌散分布�����,增強(qiáng)合金的抗菌效果���。此外,含銀銅合金的抗菌率隨與菌懸液接觸時間的延長而增大���,這是由于納米銀顆粒對細(xì)菌的抑制/殺滅作用需要一定時間。
表2 不同方法處理后經(jīng)70%變形量軋制的含銀銅合金的抗菌率
由表2可知�����,第二次抗菌試驗及經(jīng)過無菌蒸餾水沖洗再進(jìn)行抗菌試驗的經(jīng)70%變形量軋制的含銀銅合金的抗菌率較前一次試驗低����,而經(jīng)砂紙打磨后,含銀銅合金的抗菌率仍超過99.9%�����。合金表面狀態(tài)對其抗菌性能有較大影響,第一次抗菌試驗結(jié)束后��,未對表面進(jìn)行處理,細(xì)菌殘骸����、代謝產(chǎn)物等會殘留在合金表面�,阻礙表面納米銀顆粒與大腸桿菌作用,降低合金的抗菌性能���。經(jīng)過第二次無菌蒸餾水沖洗后含銀銅合金第三次抗菌試驗后的抗菌率低于第一次無菌蒸餾水沖洗+第二次抗菌試驗后���,這可能是因為含銀銅合金與大腸桿菌接觸后,表面會形成生物膜��,且隨著接觸時間以及接觸次數(shù)的增加��,生物膜密度增大��,影響納米銀顆粒與大腸桿菌作用概率����,降低合金的抗菌性能����。砂紙打磨后合金表面的生物膜等殘留物被清除干凈��,表面恢復(fù)到試驗前的狀態(tài)���,因此抗菌率仍大于99.9%�����。
3 結(jié) 論
(1) 軋制后含銀銅合金的晶粒尺寸隨軋制變形量的增加而減小����,軋制變形量為70%時平均晶粒尺寸由未軋制的143μm 減小至1.4μm�����,變形孿晶減少至基本消失��;含銀銅合金中存在納米銀顆粒�����,且在晶界處位錯墻、位錯纏結(jié)等缺陷密度較大區(qū)域偏聚�����,軋制后分布更加均勻��。
(2) 軋制有利于提高含銀銅合金的抗菌性能�����,且變形量越大�����,抗菌性能越好����,70%變形量軋制后含銀銅合金與大腸桿菌懸液接觸6h時的抗菌率超過99.9%����,抗菌效果優(yōu)異,這與提高軋制變形量可增加合金中的缺陷數(shù)量和晶界密度�����,促進(jìn)了納米銀顆粒的彌散分布有關(guān)�。含銀銅合金表面狀態(tài)對抗菌性能有較大影響��,抗菌試驗后表面未經(jīng)處理或僅用無菌蒸餾水沖洗時���,含銀銅合金的抗菌效果降低,而經(jīng)表面打磨后抗菌率仍在99.9%以上����。